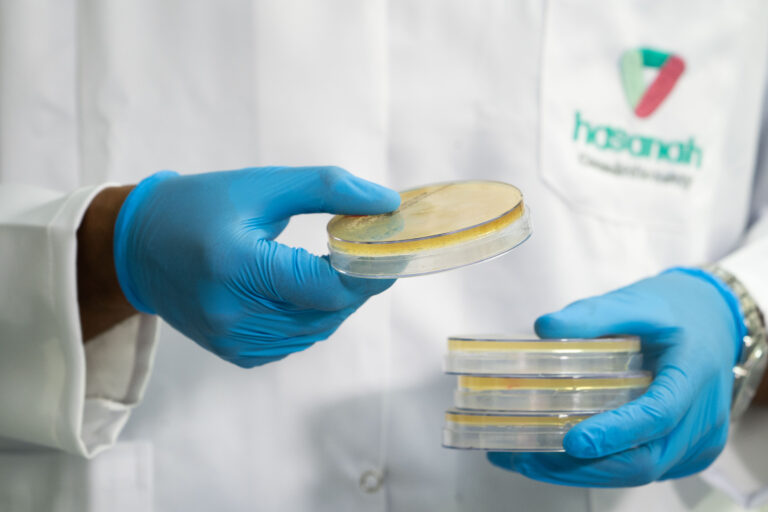

تأسست شركة حصانة سنة 2013 من قبل الأستاذ الدكتور صالح ح. سدراني رئيس مجلس الإدارة، وتميزت كواحدة من المختبرات الخاصة الرائدة في المملكة العربية السعودية.
تعد حصانة اليوم المختبر المفضل للعديد من الشركات في كل من القطاعين العام والخاص، لتقديم تحليلات كيميائية وميكروبيولوجية لمستحضرات التجميل والمنظفات والعطور والمواد الغذائية بالإضافة إلى اختبار لعب الأطفال للتأكد من سلامتها للاستخدام.


تتمثل رؤيتنا في أن نصبح رواد للتحاليل المخبرية والاستشارات في التحليلات الكيميائية والميكروبيولوجية و الضامن الرسمي لجودة المنتجات في المملكة العربية السعودية.
مهمتنا هي التفوق في تقديم خدمات استشارية واختبارات عالية جودة لعملائنا ، مع تحمل مسؤوليتنا تجاه البيئة، المجتمع والمستهلك.
تلتزم مختبراتنا بأن تكون عامل تصفية بين المصنعين والمستهلكين ، و ضامنة بأن الشركات المصنعة تزود السوق بمواد عالية الجودة تمثلهم ، وأن المجتمع يتلقى منتجات آمنة ومعتمدة بماعيير عالمية.
النزاهة والصدق هما جوهر ما تقوم به حصانة
نلتزم بالأمان والشفافية والمسؤولية تجاه تجاه البيئة، المجتمع والمستهلك
تقدم مختبرنا خدمات تركز على العملاء لضمان السلامة أولا ثم الرضا ثانيا
نعمل وفقًا للمعايير الصحة و النظافة السعودية والدولية
تتم إدارة جميع عمليات شركة حصانة بشكل مباشر والإشراف عليها من قبل إدارة تحترم القوانين والإجراءات والمعايير
عملنا تنافسي ونحب التحدي!

لدى حصانة نظام إدارة قوي يتضمن دليل الجودة والإجراءات ذات الصلة التي تصف الإرشادات النظرية والعملية لتتوافق مع معيار ISO / IEC 17025: 2017.
تولي مختبراتنا اهتماما كبيرا لمتابعة وتطبيق نظام الجودة في جميع الأقسام وخاصة فيما يتعلق بالاختبارات والنتائج.
أحدث المعايير التحليلية
المتابعة الدورية والتدريب
مسح الأدوار المعينة Clear assigned roles
تماشياً مع رؤية المملكة العربية السعودية 2030 ، تسعى شركة مختبرات حصانة التخصصية إلى لعب دورها الريادي كأحد المختبرات الخاصة التي تهتم وتختص في مجال إختبار وجودة وسلامة مختلف أنواع المنتجات ، سواء التي يتم تصنيعها داخل المملكة أو تلك التي يتم استيرادها من الخارج. نحن في مجلس إدارة الشركة لا نألو جهداً في تقديم كل الدعم اللازم والمطلوب للنهوض بمختبراتنا ورفع كفاءتها لتحقيق طموحنا وطموح قياداتنا الرشيدة في المملكة في هذا المجال.


تعرف على فريقنا المحترف والمعتمد متعدد التخصصات والذي يجعل من حصانة مختبر من الدرجة الأولى في المملكة العربية السعودية


